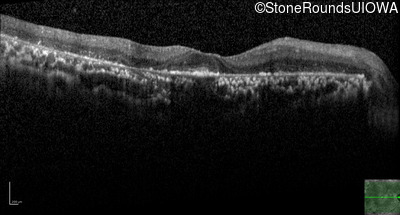
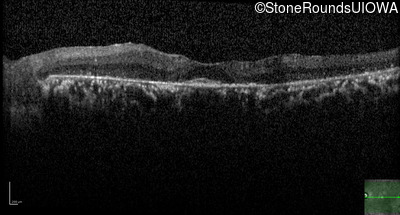

Case
SR1006
Student Mode
AR Retinitis Pigmentosa (IA1aiii)
Female
Female
Hidden
SR1006
Student Mode
AR Retinitis Pigmentosa (IA1aiii)
Female
Female
History
This 43 year old woman has had poor peripheral vision and poor night vision since childhood. She recalls sometimes having to back-up to find something she dropped on the floor. She first came to ophthalmologic attention at age 10 when there was concern for cataract formation associated with high doses of oral steroids she was receiving for asthma.
Diagnosis & molecular findings
| Disease | Gene | Allele 1 variant(s) | Allele 2 variant(s) | Inheritance mode |
|---|---|---|---|---|
| AR Retinitis Pigmentosa | TMEM216 | -69u G>T | -69u G>T | AR |
Disease:
Gene:
Allele 1:
-69u G>T
Allele 2:
-69u G>T
Inheritance:
AR